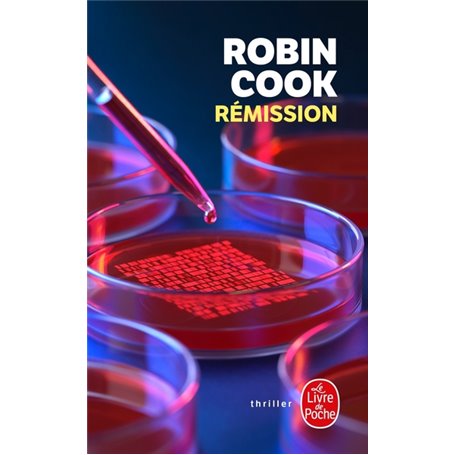
Rémission

Rémission
Editions LGF
Format PocheAuteur : Robin Cook
Format PocheAuteur : Robin Cook
10,23 €
TTC
Livraison sous 15 jours
Notes et avis clients
personne n'a encore posté d'avis
sur cet article

Livraison à la Réunion tout compris

Retours et SAV simplifiés

Ce produit dispose de la Garantie Isleden
Description
Pourquoi un chercheur japonais, spécialiste en médecine régénérative, se retrouve-t-il sur la table d'une morgue de New York ? Qui l'a entraîné aux États-Unis ? Les enjeux de sa découverte se chiffrent en milliards de dollars. De quoi susciter bien des jalousies... Robin Cook, le maître du thriller médical, entraîne les médecins légistes Laurie Montgomery et Jack Stappelton dans une nouvelle enquête où mafias japonaise et américaine et multinationales sans scrupules rivalisent de noirceur.
Un suspense à la limite du supportable. Ici Paris.
Caractéristiques
Caractéristiques
- Format
- Poche
- Auteur(s)
- Robin Cook
- Collection
- Thrillers
- Date de parution
- 05/06/2013
Livraison à la Réunion avec Isleden
🇷🇪 Commandez en ligne comme sur Amazon et profitez d’une livraison à la Réunion sans frais de douane. Avec Isleden, le prix est 100% transparent et votre commande est livrée directement chez vous ou en point de retrait, en toute simplicité.